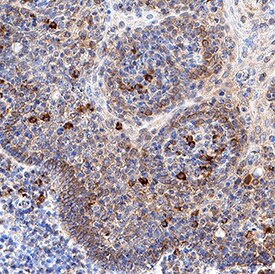

Key Product Details
Species Reactivity
Human
Applications
Immunohistochemistry
Label
Unconjugated
Antibody Source
Monoclonal Mouse IgG1 Clone # 1036431
Loading...
Product Specifications
Immunogen
Human embryonic kidney cell, HEK293 derived human B7-2/CD86
Leu26-Pro247
Accession # NP_787058
Leu26-Pro247
Accession # NP_787058
Specificity
Detects human B7-2/CD86 in direct ELISAs.
Clonality
Monoclonal
Host
Mouse
Isotype
IgG1
Scientific Data Images for Human B7‑2/CD86 Antibody
B7‑2/CD86 in Human Appendix.
B7‑2/CD86 was detected in immersion fixed paraffin-embedded sections of human appendix using Mouse Anti-Human B7‑2/CD86 Monoclonal Antibody (Catalog # MAB108521) at 5 µg/mL for 1 hour at room temperature followed by incubation with the Anti-Mouse IgG VisUCyte™ HRP Polymer Antibody (VC001). Before incubation with the primary antibody, tissue was subjected to heat-induced epitope retrieval using Antigen Retrieval Reagent-Basic (CTS013). Tissue was stained using DAB (brown) and counterstained with hematoxylin (blue). Specific staining was localized to lymphocytes in appendix. Staining was performed using our protocol for IHC Staining with VisUCyte HRP Polymer Detection Reagents.Applications for Human B7‑2/CD86 Antibody
Application
Recommended Usage
Immunohistochemistry
5-25 µg/mL
Sample: Immersion fixed paraffin-embedded sections of human appendix
Sample: Immersion fixed paraffin-embedded sections of human appendix
Formulation, Preparation, and Storage
Purification
Protein A or G purified from hybridoma culture supernatant
Reconstitution
Reconstitute at 0.5 mg/mL in sterile PBS. For liquid material, refer to CoA for concentration.
Loading...
Formulation
Lyophilized from a 0.2 μm filtered solution in PBS with Trehalose. *Small pack size (SP) is supplied either lyophilized or as a 0.2 µm filtered solution in PBS.
Shipping
Lyophilized product is shipped at ambient temperature. Liquid small pack size (-SP) is shipped with polar packs. Upon receipt, store immediately at the temperature recommended below.
Stability & Storage
Use a manual defrost freezer and avoid repeated freeze-thaw cycles.
- 12 months from date of receipt, -20 to -70 °C as supplied.
- 1 month, 2 to 8 °C under sterile conditions after reconstitution.
- 6 months, -20 to -70 °C under sterile conditions after reconstitution.
Calculators
Background: B7-2/CD86
References
- Greenwald, R.J. et al. (2005) Annu. Rev. Immunol. 23:515.
- Bour-Jordan, H. et al. (2011) Immunol. Rev. 241:180.
- Freeman, G.J. et al. (1993) Science 262:909.
- Azuma, M. et al. (1993) Nature 366:76.
- Freeman, G.J. et al. (1993) J. Exp. Med. 178:2185.
- Lenschow, D.J. et al. (1993) Proc. Natl. Acad. Sci. USA 90:11054.
- Hathcock, K.S. et al. (1993) Science 262:905.
- Seino, K. et al. (1995) Int. Immunol. 7:1331.
- Chen, C. et al. (1994) J. Immunol. 152:4929.
- Lanier, L.L. et al. (1995) J. Immunol. 154:97.
- Rudd, C.E. et al. (2009) Immunol. Rev. 229:12.
- Wing, K. et al. (2011) Trends Immunol. 32:428.
- Pentcheva-Hoang, T. et al. (2004) Immunity 21:401.
- Kuchroo, V.K. et al. (1995) Cell 80:707.
- Short, J.J. et al. (2006) Virus Res. 122:144.
Alternate Names
B72, CD86
Gene Symbol
CD86
UniProt
Additional B7-2/CD86 Products
Product Documents for Human B7‑2/CD86 Antibody
Certificate of Analysis
To download a Certificate of Analysis, please enter a lot or batch number in the search box below.
Note: Certificate of Analysis not available for kit components.
Product Specific Notices for Human B7‑2/CD86 Antibody
For research use only
Customer Reviews for Human B7‑2/CD86 Antibody
There are currently no reviews for this product. Be the first to review Human B7‑2/CD86 Antibody and earn rewards!
Have you used Human B7‑2/CD86 Antibody?
Submit a review and receive an Amazon gift card!
$25/€18/£15/$25CAN/¥2500 Yen for a review with an image
$10/€7/£6/$10CAN/¥1110 Yen for a review without an image
Submit a review
Protocols
Find general support by application which include: protocols, troubleshooting, illustrated assays, videos and webinars.
- Antigen Retrieval Protocol (PIER)
- Antigen Retrieval for Frozen Sections Protocol
- Appropriate Fixation of IHC/ICC Samples
- Cellular Response to Hypoxia Protocols
- Chromogenic IHC Staining of Formalin-Fixed Paraffin-Embedded (FFPE) Tissue Protocol
- Chromogenic Immunohistochemistry Staining of Frozen Tissue
- ClariTSA™ Fluorophore Kits
- Detection & Visualization of Antibody Binding
- Fluorescent IHC Staining of Frozen Tissue Protocol
- Graphic Protocol for Heat-induced Epitope Retrieval
- Graphic Protocol for the Preparation and Fluorescent IHC Staining of Frozen Tissue Sections
- Graphic Protocol for the Preparation and Fluorescent IHC Staining of Paraffin-embedded Tissue Sections
- Graphic Protocol for the Preparation of Gelatin-coated Slides for Histological Tissue Sections
- IHC Sample Preparation (Frozen sections vs Paraffin)
- Immunofluorescent IHC Staining of Formalin-Fixed Paraffin-Embedded (FFPE) Tissue Protocol
- Immunohistochemistry (IHC) and Immunocytochemistry (ICC) Protocols
- Immunohistochemistry Frozen Troubleshooting
- Immunohistochemistry Paraffin Troubleshooting
- Preparing Samples for IHC/ICC Experiments
- Preventing Non-Specific Staining (Non-Specific Binding)
- Primary Antibody Selection & Optimization
- Protocol for Heat-Induced Epitope Retrieval (HIER)
- Protocol for Making a 4% Formaldehyde Solution in PBS
- Protocol for VisUCyte™ HRP Polymer Detection Reagent
- Protocol for the Preparation & Fixation of Cells on Coverslips
- Protocol for the Preparation and Chromogenic IHC Staining of Frozen Tissue Sections
- Protocol for the Preparation and Chromogenic IHC Staining of Frozen Tissue Sections - Graphic
- Protocol for the Preparation and Chromogenic IHC Staining of Paraffin-embedded Tissue Sections
- Protocol for the Preparation and Chromogenic IHC Staining of Paraffin-embedded Tissue Sections - Graphic
- Protocol for the Preparation and Fluorescent IHC Staining of Frozen Tissue Sections
- Protocol for the Preparation and Fluorescent IHC Staining of Paraffin-embedded Tissue Sections
- Protocol for the Preparation of Gelatin-coated Slides for Histological Tissue Sections
- TUNEL and Active Caspase-3 Detection by IHC/ICC Protocol
- The Importance of IHC/ICC Controls
- Troubleshooting Guide: Immunohistochemistry
- View all Protocols, Troubleshooting, Illustrated assays and Webinars




